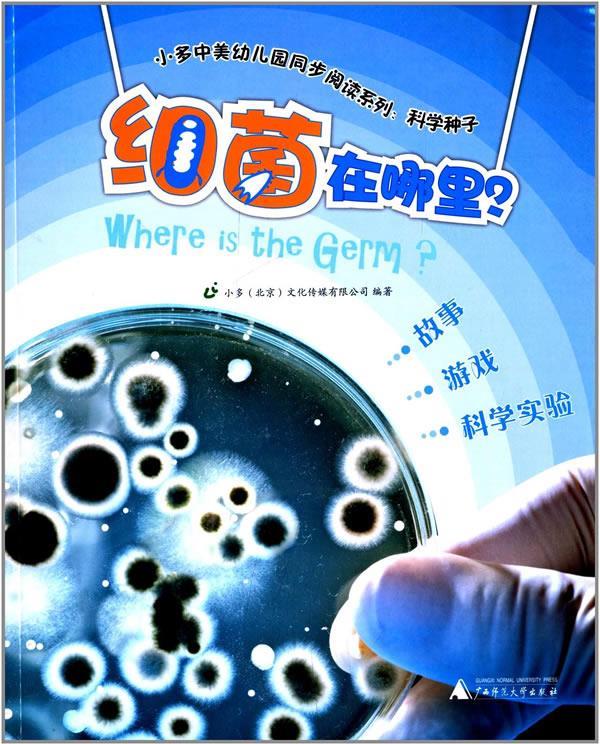
张大嘴巴

嘴巴 张大

男子看牙医嘴巴张不大,女助理一招解决,果然男人本性都好色!
图片尺寸1142x2030
注视,黄种人,观察,看,张嘴,摄影,影棚,观看,察看,关注,张大嘴巴,年轻
图片尺寸615x819
哦,天哪! 疯狂的,震惊的年轻人大喊着,张大嘴巴看着摄像机
图片尺寸700x467
冬天里张大嘴巴的猫高清图片
图片尺寸1100x733
小猫做核酸92.小猫你好,要张大嘴巴发"啊~"的声音,小猫: - 抖音
图片尺寸1616x1080
喵星人张大嘴巴
图片尺寸337x506
张大嘴巴的女人
图片尺寸661x1000
张大嘴巴的猩猩图片
图片尺寸700x700
原来猫的嘴巴可以张得这么大,毕竟是噬元兽
图片尺寸640x853
张大嘴巴
图片尺寸600x744
空气又那么好吃吗?把嘴巴张这么大
图片尺寸642x360
张大嘴巴的猩猩
图片尺寸1024x1024
蓝色背景,检查,反射,分析,科学,放大镜,注视,黄种人,观察,看,站着
图片尺寸655x819
张大嘴巴的小熊卡通
图片尺寸610x610
张大嘴巴卡通人
图片尺寸350x350
十几岁的女孩得张大了嘴巴
图片尺寸700x565
垂直拍摄的目瞪口呆的年轻男子张着大嘴巴,非常惊讶,非常情绪化,表达
图片尺寸800x1200
激动的男子举起拳头,张大嘴巴,在摄影棚拍摄
图片尺寸952x1200
张大嘴巴的孩子
图片尺寸797x1200
张一张嘴就能破纪录!美国男孩的大嘴巴天赋异禀,轻松挑战吉尼斯
图片尺寸615x796